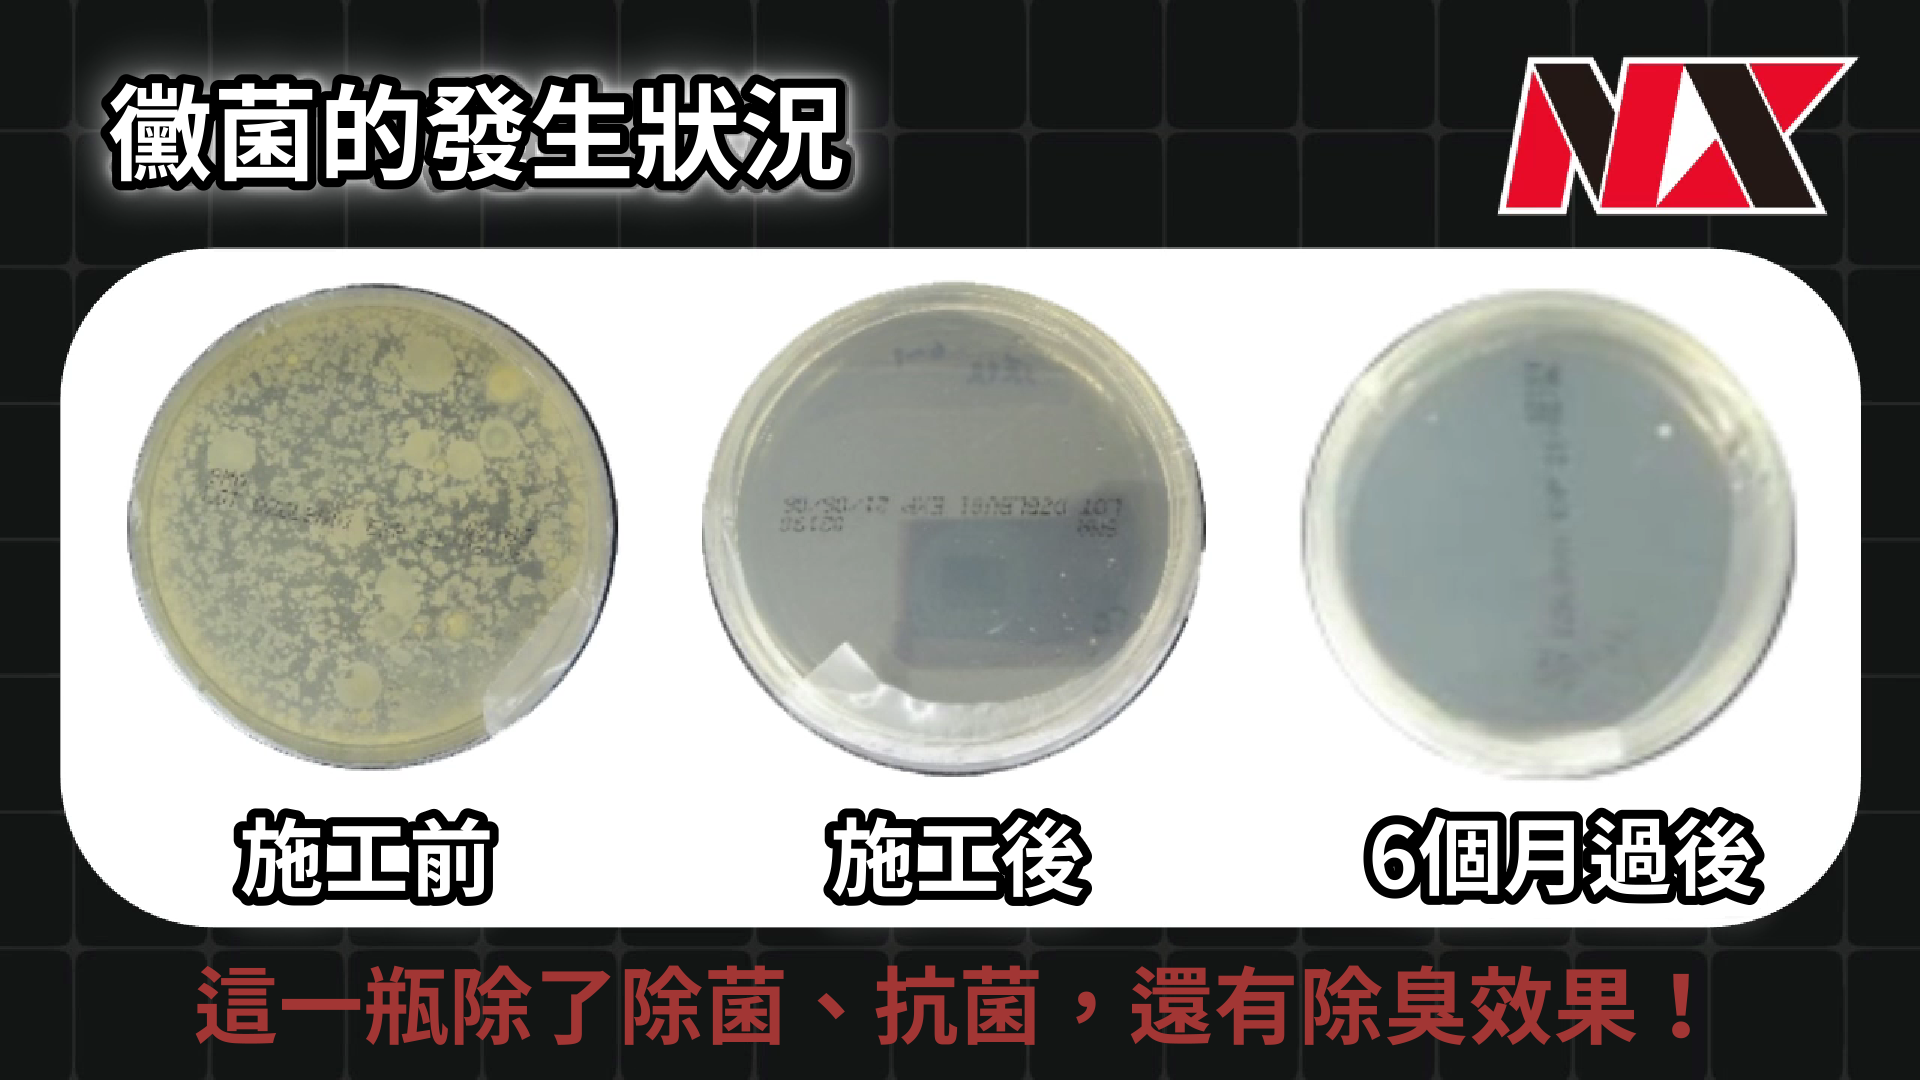
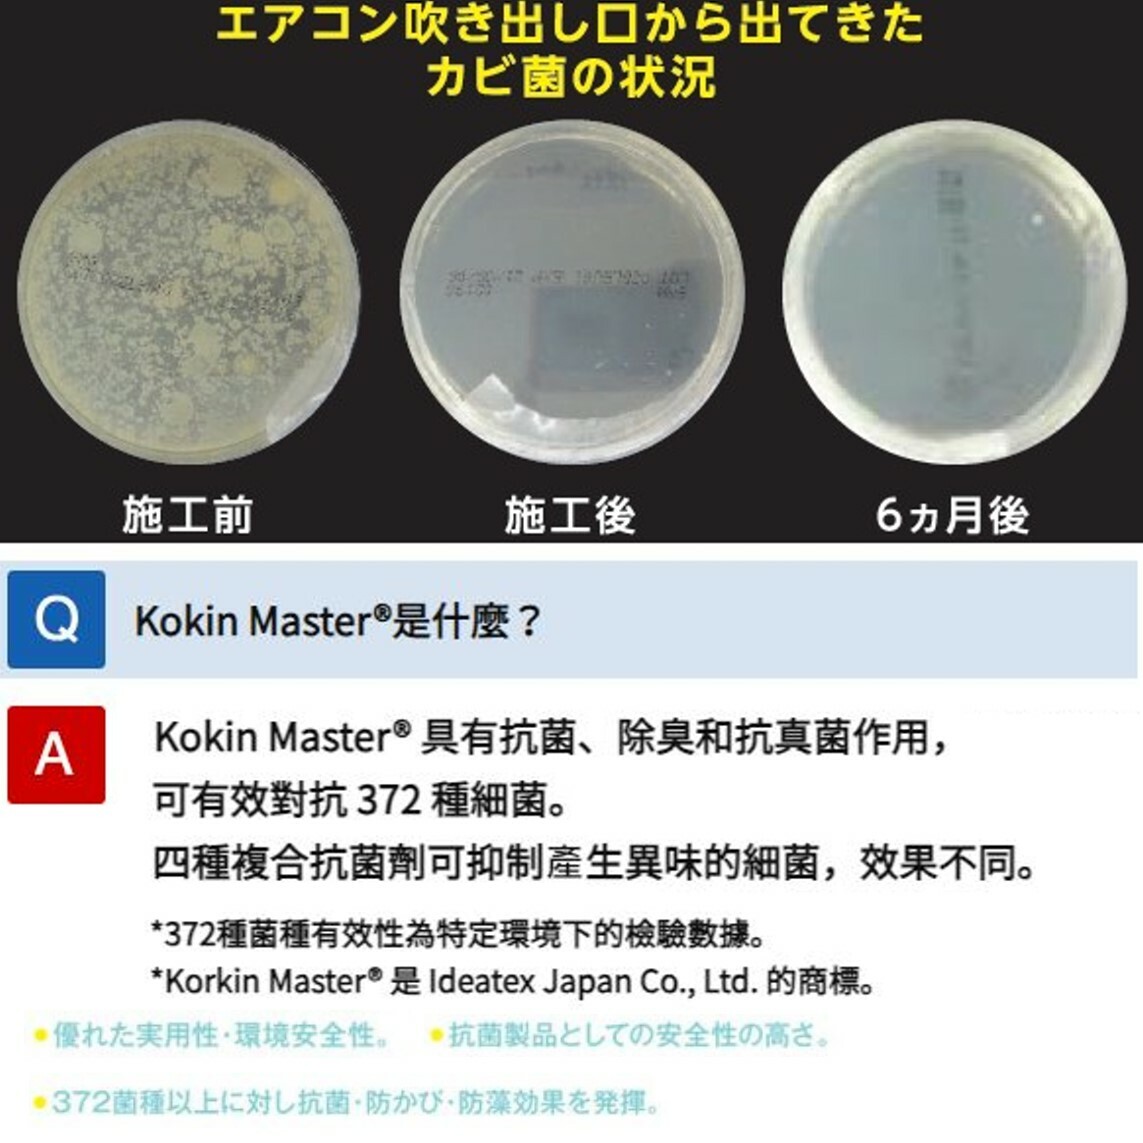

{{ 'fb_in_app_browser_popup.desc' | translate }} {{ 'fb_in_app_browser_popup.copy_link' | translate }}
{{ 'in_app_browser_popup.desc' | translate }}
{{word('consent_desc')}} {{word('read_more')}}
{{setting.description}}
{{ childProduct.title_translations | translateModel }}
{{ getChildVariationShorthand(childProduct.child_variation) }}
{{ getSelectedItemDetail(selectedChildProduct, item).childProductName }} x {{ selectedChildProduct.quantity || 1 }}
{{ getSelectedItemDetail(selectedChildProduct, item).childVariationName }}
分類
可快速消除蒸發器上的污垢、灰塵及微生物,提昇車內冷房效率與品質,採用世界首創 KOKINMASTER® 除臭抑菌配方,在表面形成保護層,延緩污物再次累積,經實驗證明,可對372種類的霉菌、細菌、藻類具有除菌及抗菌防霉效果,保持空調統內部清潔。
商品存貨不足,未能加入購物車
您所填寫的商品數量超過庫存
{{'products.quick_cart.out_of_number_hint'| translate}}
{{'product.preorder_limit.hint'| translate}}
每筆訂單限購 {{ product.max_order_quantity }} 件
現庫存只剩下 {{ quantityOfStock }} 件

© 2015-2026 Copyright: JIA YUN TRADING COMPANY





